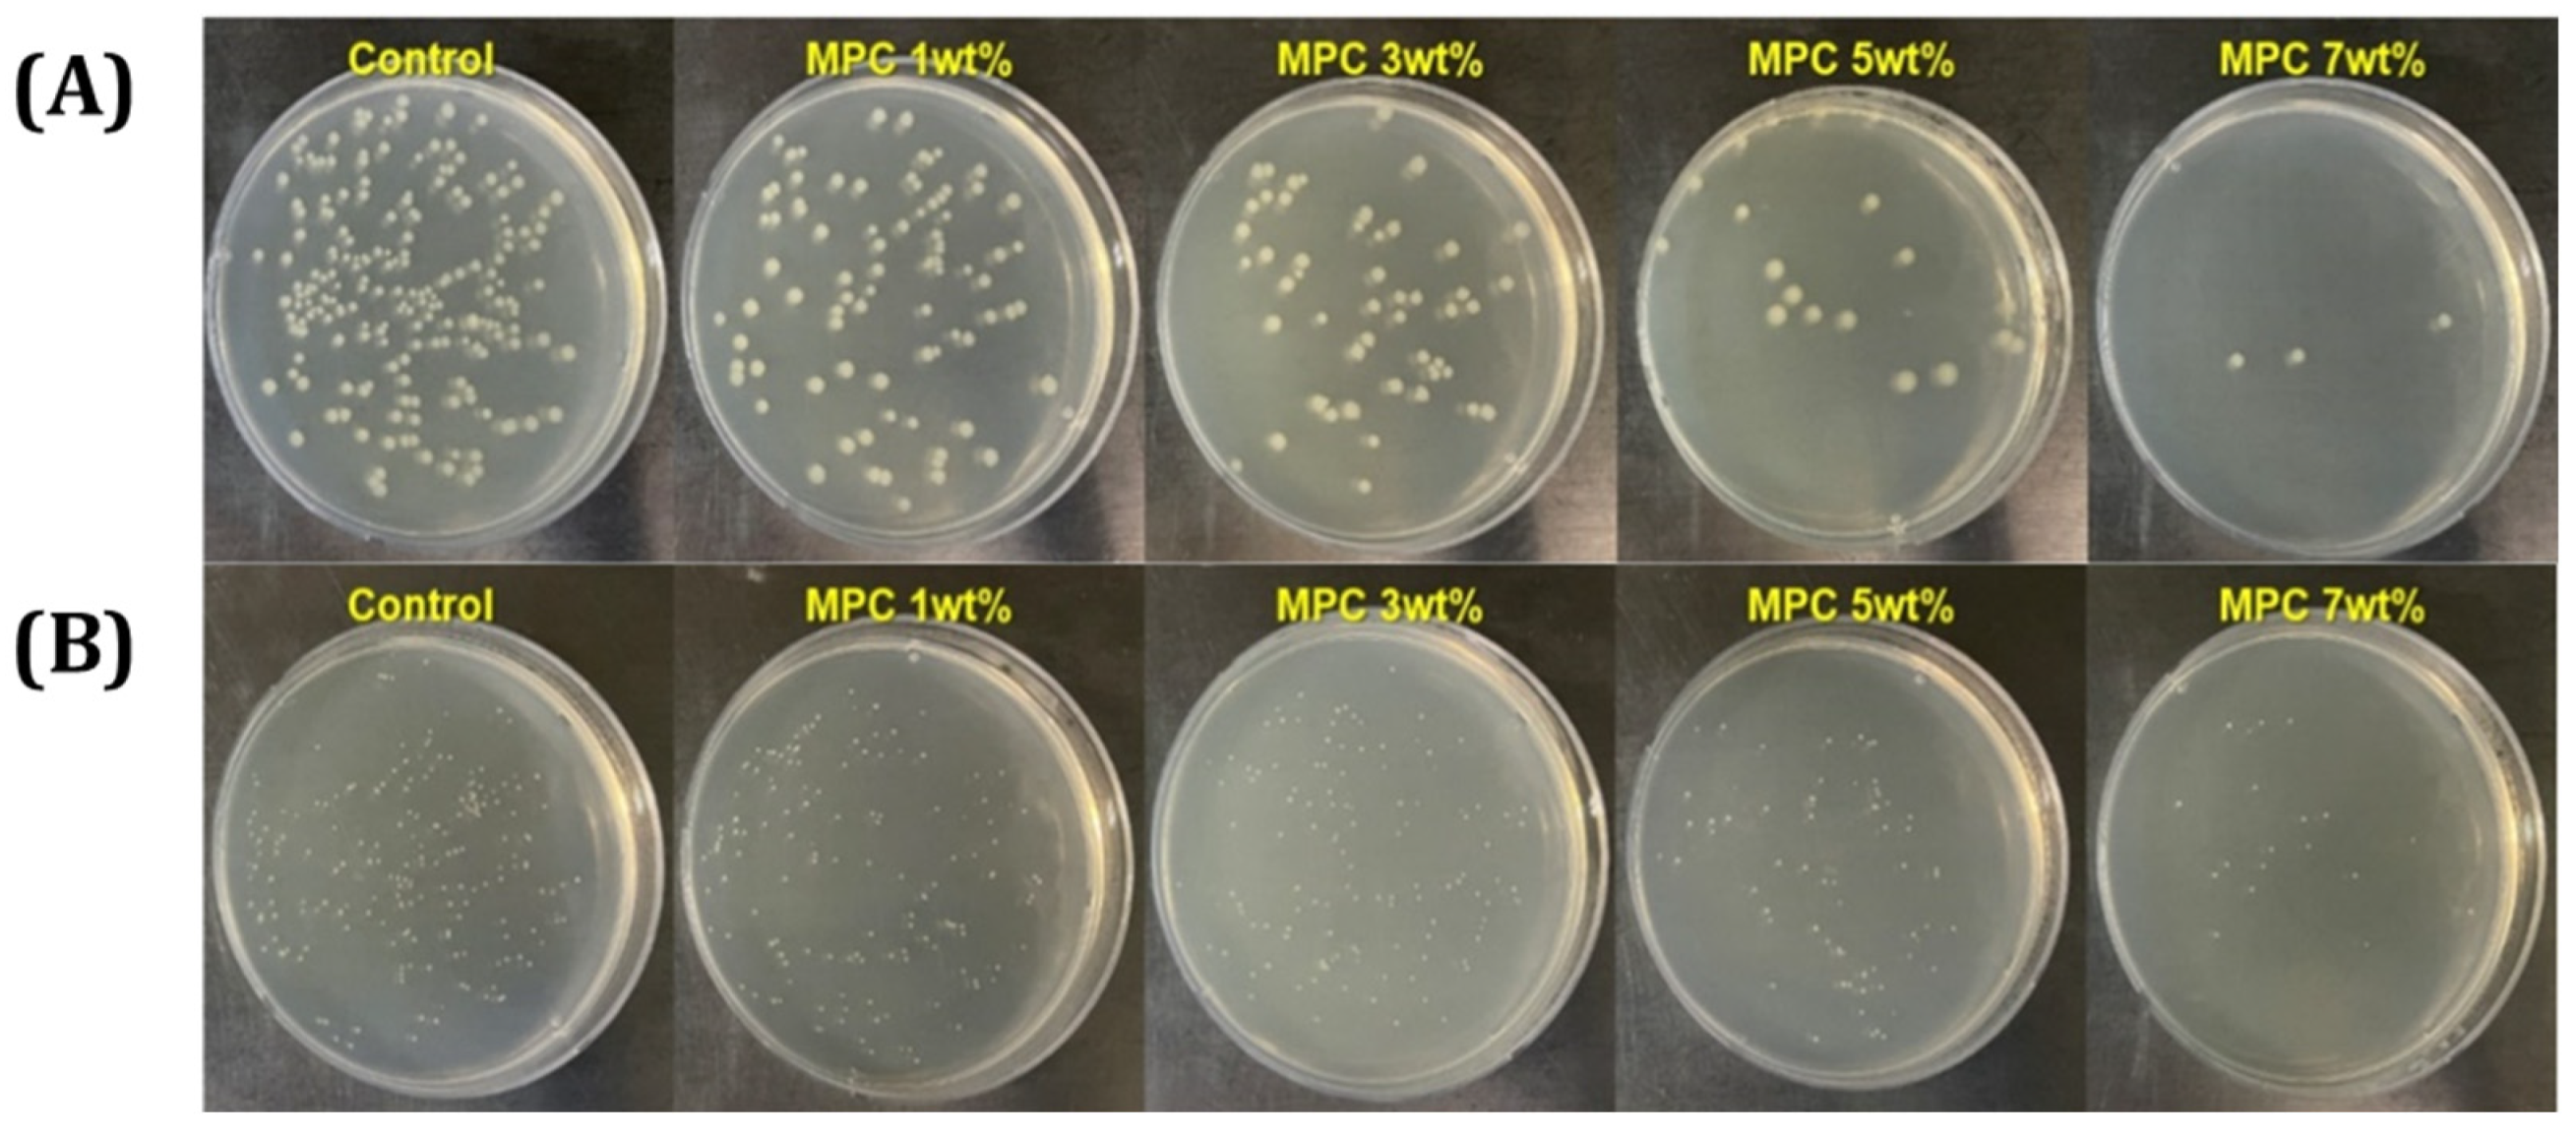
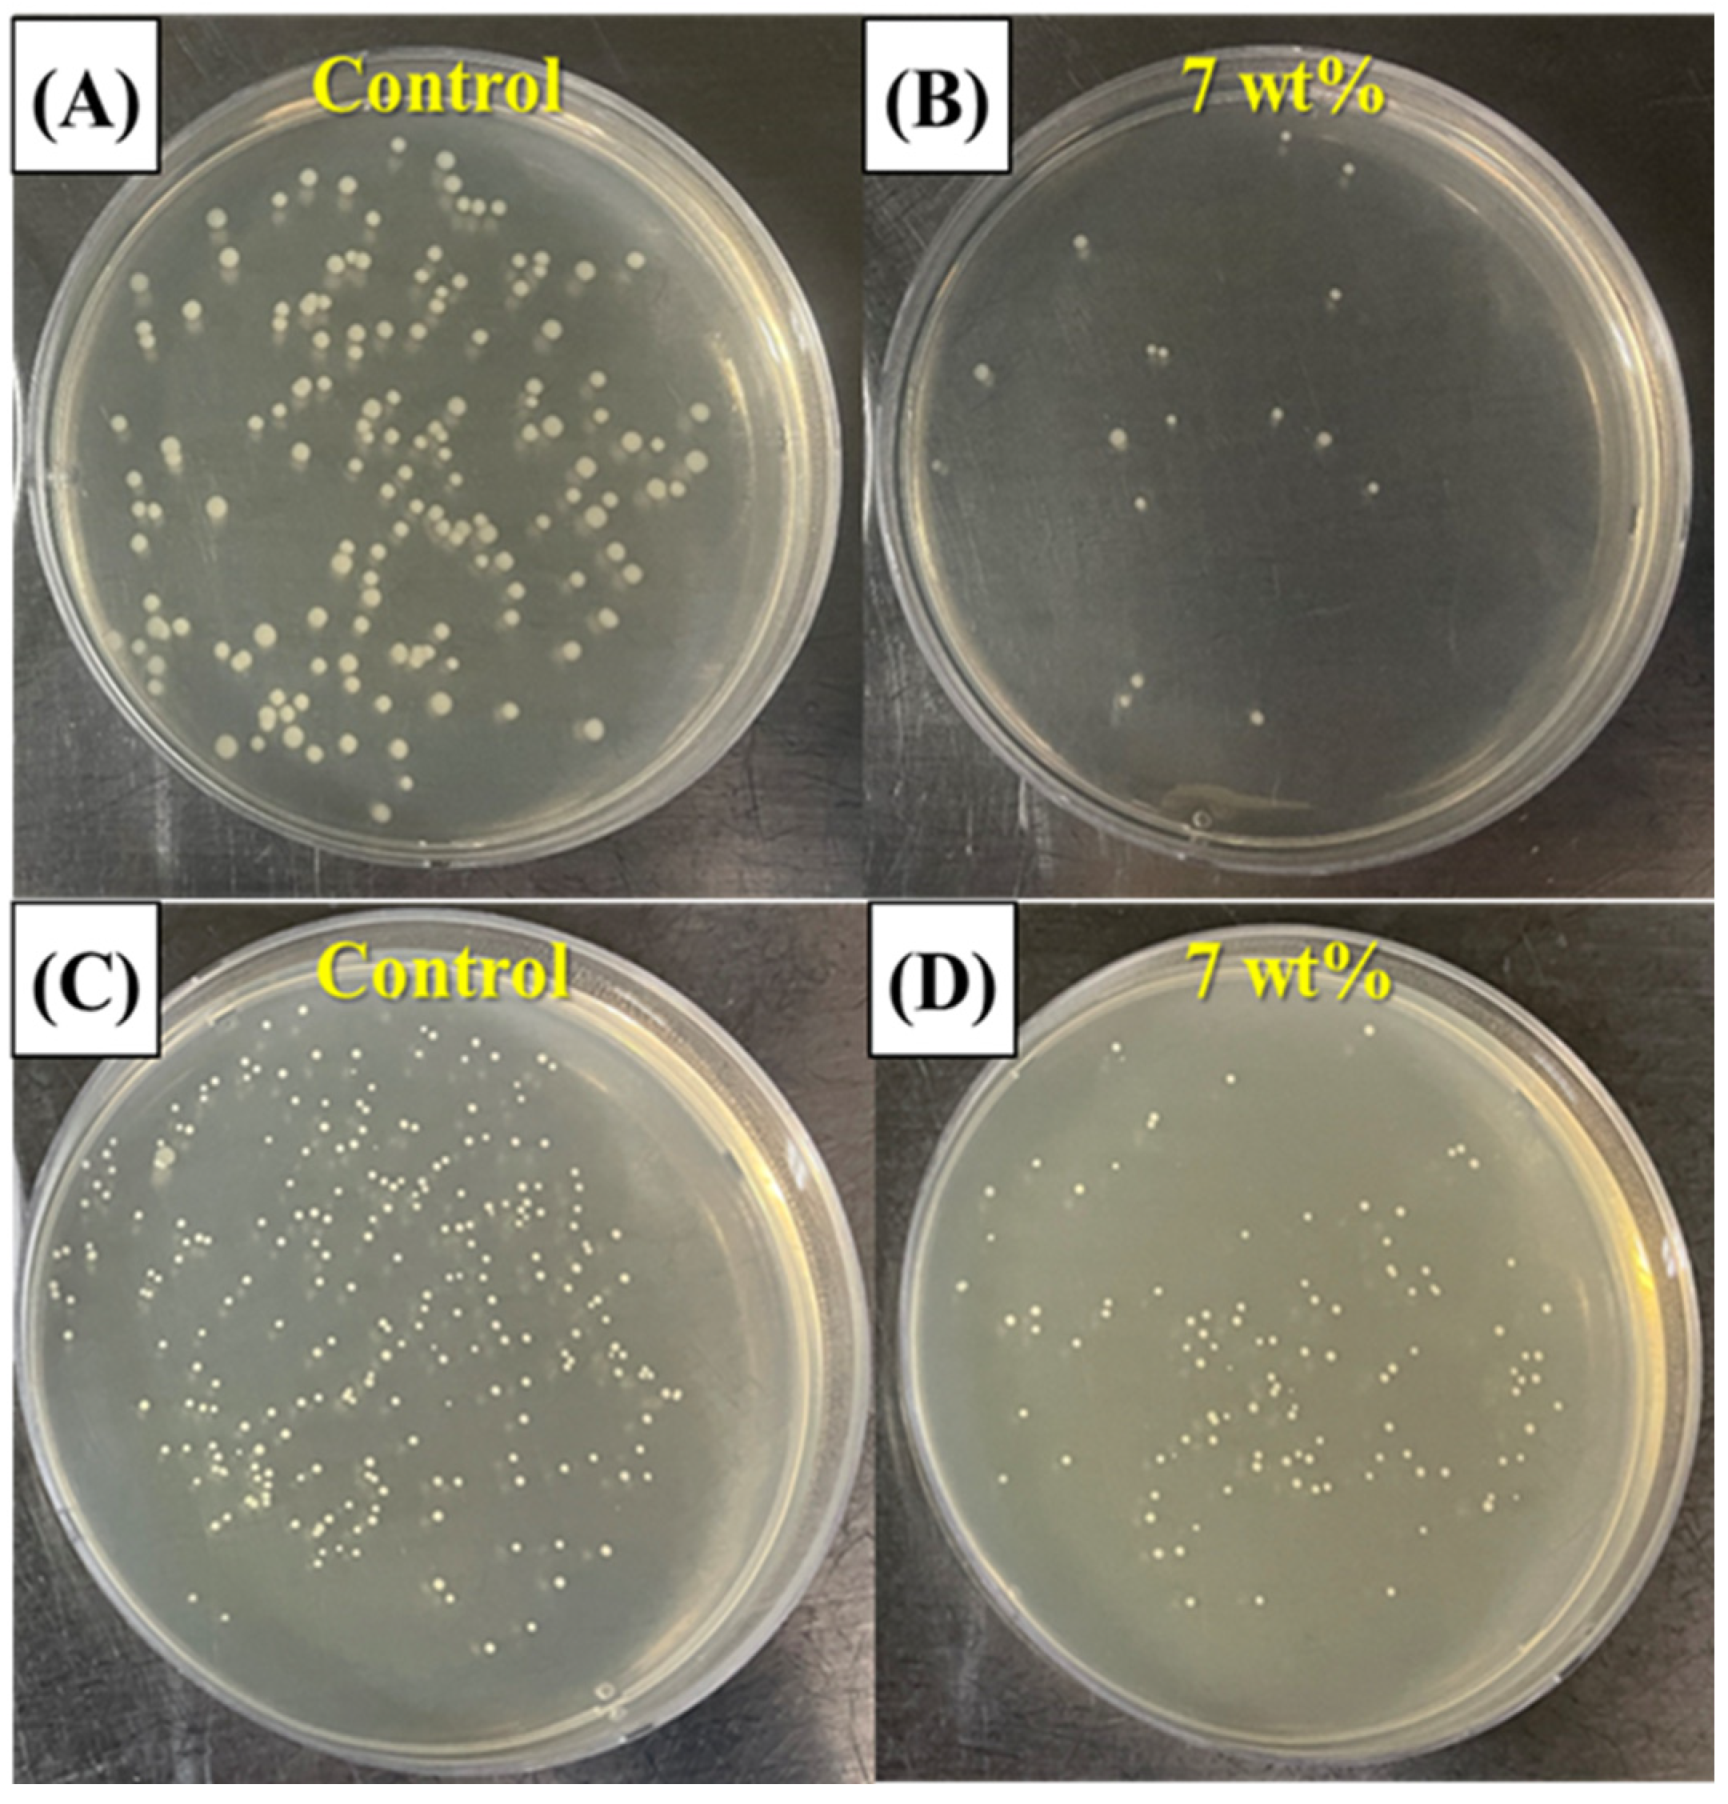

Resin Composites with Anti-Biofouling Zwitterionic Polymer and Silica/Zirconia Filler for Digital Light Processing (DLP) of Dental Protheses
Abstract
1. Introduction
2. Materials and Methods
2.1. Constituents of Photocurable Resin Composite Suspension
2.2. MPC-Incorporated Resin Matrix Preparation
2.3. Resin Composite with Inorganic Filler
2.4. DLP Process for Specimen Preparation
2.5. Photocurable Behavior Analysis
2.6. Mechanical Properties Measurement
2.7. Bacterial Adhesion Analysis
2.8. Protein Adsorption Test
2.9. Statistical Analysis
3. Results and Discussion
3.1. Rheological Behavior of MPC-Incorporated Resin Matrix
3.2. Photopolymerization Behavior of MPC-Incorporated Resin Matrix
3.3. Mechanical Properties of Resin Incorporated with MPC
3.4. Bacterial Adhesion Test of Resin Incorporated with MPC
3.5. Protein-Repelling Ability Test
3.6. Characterization of γ-MPS-Treated Silica-Zirconia Inorganic Filler
3.7. Rheological Behavior of γ-MPS-Treated Silica-Zirconia-Filled Resin Composite
3.8. Mechanical Properties of Resin Composite
3.9. Microstructure Assessment
3.10. Anti-Biofouling Ability
4. Conclusions
Author Contributions
Funding
Institutional Review Board Statement
Informed Consent Statement
Data Availability Statement
Conflicts of Interest
References
- Rezaie, F.; Farshbaf, M.; Dahri, M.; Masjedi, M.; Maleki, R.; Amini, F.; Wirth, J.; Moharamzadeh, K.; Weber, F.E.; Tayebi, L. 3D printing of dental prostheses: Current and emerging applications. J. Compos. Sci. 2023, 7, 80. [Google Scholar] [CrossRef] [PubMed]
- Jeong, M.; Radomski, K.; Lopez, D.; Liu, J.T.; Lee, J.D.; Lee, S.J. Materials and applications of 3D printing technology in dentistry: An overview. Dent. J. 2024, 12, 1. [Google Scholar] [CrossRef]
- Chaudhary, R.; Fabbri, P.; Leoni, E. Additive manufacturing by digital light processing: A review. Prog. Addit. Manuf. 2023, 8, 331–351. [Google Scholar] [CrossRef]
- Cho, K.; Rajan, G.; Farrar, P.; Prentice, L.; Prusty, B.G. Dental resin composites: A review on materials to product realizations. Compos. Part B Eng. 2022, 230, 109495. [Google Scholar] [CrossRef]
- Lakkala, P.; Munnangi, S.R.; Bandari, S.; Repka, M. Additive manufacturing technologies with emphasis on stereolithography 3D printing in pharmaceutical and medical applications: A review. Int. J. Pharm. X 2023, 5, 100159. [Google Scholar] [CrossRef] [PubMed]
- Rashid, A.A.; Ahmed, W.; Khalid, M.Y.; Koç, M. Vat photopolymerization of polymers and polymer composites: Processes and applications. Addit. Manuf. 2021, 47, 102279. [Google Scholar] [CrossRef]
- Hassanpour, M.; Farahani, R.D.; Dehghani, S.; Tavangar, M.; Nouri, A.; Maleki, R.; Tayebi, L. Effects of Post-Processing Parameters on 3D-Printed Dental Appliances: A Review. Polymers 2024, 16, 2795. [Google Scholar] [CrossRef]
- Mobarak, M.H.; Hasan, M.; Islam, M.T.; Reza, A.; Siddiquee, M.A. Recent advances of additive manufacturing in implant fabrication–A review. Appl. Surf. Sci. Adv. 2023, 18, 100462. [Google Scholar] [CrossRef]
- Dimitrova, M.; Vlahova, A.; Kalachev, Y.; Zlatev, S.; Kazakova, R.; Capodiferro, S. Recent Advances in 3D Printing of Polymers for Application in Prosthodontics. Polymers 2023, 15, 4525. [Google Scholar] [CrossRef]
- Lin, L.; Fang, Y.; Liao, Y.; Chen, G.; Gao, C.; Zhu, P. 3D printing and digital processing techniques in dentistry: A review of literature. Adv. Eng. Mater. 2019, 21, 1801013. [Google Scholar] [CrossRef]
- Moon, W.; Kim, S.; Lim, B.-S.; Park, Y.-S.; Kim, R.J.-Y.; Chung, S.H. Dimensional accuracy evaluation of temporary dental restorations with different 3D printing systems. Materials 2021, 14, 1487. [Google Scholar] [CrossRef]
- Wuersching, S.N.; Hickel, R.; Edelhoff, D.; Kollmuss, M. Initial biocompatibility of novel resins for 3D printed fixed dental prostheses. Dent. Mater. 2022, 38, 1587–1597. [Google Scholar] [CrossRef]
- Dureja, A.; Acharya, S.R.; Kini, S.; Mayya, A.; Hedge, V. Biocompatibility and performance of dental composite restorations: A narrative review on free monomer release, concerns and solutions. Eng. Proc. 2023, 59, 160. [Google Scholar]
- Flemming, H.C.; Wingender, J.; Szewzyk, U.; Steinberg, P.; Rice, S.A.; Kjelleberg, S. Biofilms: An emergent form of bacterial life. Nat. Rev. Microbiol. 2016, 14, 563–575. [Google Scholar] [CrossRef]
- Karygianni, L.; Al-Ahmad, A.; Kagami, R.; Johannsmeier, L.; Follo, M.; Adolfsson, E.; Hellwig, E.; Argyropoulou, A. Biofilm Matrixome: Extracellular Components in Structured Microbial Communities. Trends Microbiol. 2020, 28, 668–681. [Google Scholar] [CrossRef] [PubMed]
- Liu, B.H.; Yu, L.C. In-situ, time-lapse study of extracellular polymeric substance discharge in Streptococcus mutans biofilm. Colloids Surf. B Biointerfaces 2017, 150, 98–105. [Google Scholar] [CrossRef]
- Orman, M.A.; Brynildsen, M.P. Inhibition of stationary phase respiration impairs persister formation in E. coli. Nat. Commun. 2015, 6, 7983. [Google Scholar] [CrossRef] [PubMed]
- Enning, D.; Garrelfs, J. Corrosion of iron by sulfate-reducing bacteria: New views of an old problem. Appl. Environ. Microbiol. 2014, 80, 1226–1236. [Google Scholar] [CrossRef]
- Xu, W.; Yu, F.; Addison, O.; Zhang, B.; Guan, F.; Zhang, R.; Hou, B.; Sand, W. Microbial Corrosion of Metallic Biomaterials in the Oral Environment. Acta Biomater. 2024, 184, 22–36. [Google Scholar] [CrossRef] [PubMed]
- Simon-Soro, A.; Mira, A. Solving the etiology of dental caries. Trends Microbiol. 2015, 23, 76–82. [Google Scholar] [CrossRef] [PubMed]
- Riool, M.; de Boer, L.; Jaspers, V.; van der Loos, C.M.; van Wamel, W.J.B.; Wu, G.; Kwakman, P.H.S.; Zaat, S.A.J. Staphylococcus epidermidis originating from titanium implants infects surrounding tissue and immune cells. Acta Biomater. 2014, 10, 5202–5212. [Google Scholar] [CrossRef]
- Raphel, J.; Holodniy, M.; Goodman, S.B.; Heilshorn, S.C. Multifunctional coatings to simultaneously promote osseointegration and prevent infection of orthopaedic implants. Biomaterials 2016, 84, 301–314. [Google Scholar] [CrossRef] [PubMed]
- Vernon, J.J.; Raïf, E.M.; Aw, J.; Attenborough, E.; Jha, A.; Do, T. Dental Implant Surfaces and Their Interaction with the Oral Microbiome. Dent. Rev. 2022, 2, 100060. [Google Scholar] [CrossRef]
- Esposito, M.M.; Glazer, J.R.; Turku, S. The Use of 3D Printing and Nanotechnologies to Prevent and Inhibit Biofilms on Medical Devices. Hygiene 2023, 3, 325–338. [Google Scholar] [CrossRef]
- Cabrol, A.; Chuy, V.; Fron-Chabouis, H.; Naveau, A. Effectiveness of postprocessing on 3D-printed resin biocompatibility in prosthodontics: A systematic review. J. Prosthet. Dent. 2024; in press. [Google Scholar]
- Zhang, J.S.; Yang, Y.J.; Chen, Y.Q.; Chen, X.; Li, A.; Wang, J.; Shen, D.J.; Zheng, S.L. A review of new generation of dental restorative resin composites with antibacterial, remineralizing and self-healing capabilities. Discov. Nano 2024, 19, 189. [Google Scholar] [CrossRef]
- Bajunaid, S.O.; Baras, B.H.; Balhaddad, A.A.; Weir, M.D.; Xu, H.H.K. Antibiofilm and Protein-Repellent Polymethylmethacrylate Denture Base Acrylic Resin for Treatment of Denture Stomatitis. Materials 2021, 14, 1067. [Google Scholar] [CrossRef]
- Yang, H.; Xie, X.J.; Li, X.W.; Bai, Y.X. Polymethyl methacrylate resin containing ε-poly-L-lysine and 2-methacryloyloxyethyl phosphorylcholine with antimicrobial effects. J. Prosthet. Dent. 2023, 129, 228.e1–228.e8. [Google Scholar] [CrossRef]
- Mangal, U.; Kwon, J.-S.; Choi, S.-H. Bio-Interactive Zwitterionic Dental Biomaterials for Improving Biofilm Resistance: Characteristics and Applications. Int. J. Mol. Sci. 2020, 21, 9087. [Google Scholar] [CrossRef]
- Zhou, X.X.; Huang, X.Y.; Li, M.Y.; Peng, X.; Wang, S.P.; Zhou, X.D.; Cheng, L. Development and status of resin composite as dental restorative materials. J. Appl. Polym. Sci. 2019, 136, 48180. [Google Scholar] [CrossRef]
- Ishihara, K.; Nomura, H.; Mihara, T.; Kurita, K.; Iwasaki, Y.; Nakabayashi, N. Why do phospholipid polymers reduce protein adsorption? J. Biomed. Mater. Res. 1998, 39, 323–330. [Google Scholar] [CrossRef]
- Sibarani, J.; Takai, M.; Ishihara, K. Surface modification on microfluidic devices with 2-methacryloyloxyethyl phosphorylcholine polymers for reducing unfavorable protein adsorption. Colloids Surf. B Biointerfaces 2007, 54, 88–93. [Google Scholar] [CrossRef]
- Chenicheri, S.; Usha, R.; Ramachandran, R.; Thomas, V.; Wood, A. Insight into Oral Biofilm: Primary, Secondary and Residual Caries and Phyto-Challenged Solutions. Open Dent. J. 2017, 11, 312–333. [Google Scholar] [CrossRef] [PubMed]
- Kim, H.T.; Çakmak, G.; Lee, Y.H.; Jo, Y.H.; Yoon, H.I.; Yilmaz, B. Mechanical properties, cytotoxicity, and protein adsorption of three-dimensionally printable hybrid resin containing zwitterionic polymer and silicate-based composites for dental restorations. J. Dent. 2024, 147, 105134. [Google Scholar] [CrossRef]
- Nagai, N.; Sakurai, S.; Seiriki, R.; Minami, M.; Yamaguchi, M.; Deguchi, S.; Harata, E. MPC polymer promotes recovery from dry eye via stabilization of the ocular surface. Pharmaceutics 2021, 13, 168. [Google Scholar] [CrossRef]
- Zhang, N.; Ma, J.; Melo, M.A.S.; Weir, M.D.; Bai, Y.; Xu, H.H.K. A Novel Protein-Repellent Dental Composite Containing 2-Methacryloyloxyethyl Phosphorylcholine. Int. J. Oral Sci. 2015, 7, 103–109. [Google Scholar] [CrossRef]
- Chen, D.W.; Lin, C.C.; Chang, Y.; Chen, C.J.; Lin, S.P.; Hsu, S.C.; Liao, W.H.; Chen, Y.C.; Wang, T.Y. Osteoblast Biocompatibility and Antibacterial Effects Using 2-Methacryloyloxyethyl Phosphocholine-Grafted Stainless-Steel Composite for Implant Applications. Nanomaterials 2019, 9, 939. [Google Scholar] [CrossRef]
- Xue, J.; Wang, J.; Feng, D.; Huang, H.; Wang, M. Application of Antimicrobial Polymers in the Development of Dental Resin Composite. Molecules 2020, 25, 4738. [Google Scholar] [CrossRef] [PubMed]
- Jiao, Y.; Niu, L.N.; Ma, S.; Li, J.; Tay, F.R.; Chen, J.H. Quaternary ammonium-based biomedical materials: State-of-the-art, toxicological aspects and antimicrobial resistance. Prog. Polym. Sci. 2017, 71, 53–90. [Google Scholar] [CrossRef] [PubMed]
- Nowak, J.; Zalega, M.; Jakubowski, W.; Domarecka, M.; Sokołowski, J.; Bociong, K. Enhancing the Antimicrobial Properties of Experimental Resin-Based Dental Composites through the Addition of Quaternary Ammonium Salts. J. Funct. Biomater. 2024, 15, 213. [Google Scholar] [CrossRef]
- Mamidi, N.; Flores Otero, J.F. Metallic and carbonaceous nanoparticles for dentistry applications. Curr. Opin. Biomed. Eng. 2023, 25, 100436. [Google Scholar] [CrossRef]
- Pratap, B.; Gupta, R.K.; Bhardwaj, B.; Nag, M. Resin-based restorative dental materials: Characteristics and future perspectives. Jpn. Dent. Sci. Rev. 2019, 55, 126–138. [Google Scholar] [CrossRef] [PubMed]
- Kowalska, A.; Sokolowski, J.; Bociong, K. The photoinitiators used in resin-based dental composite—A review and future perspectives. Polymers 2021, 13, 470. [Google Scholar] [CrossRef]
- Wu, K.C.; Halloran, J. Photopolymerization monitoring of ceramic stereolithography resins by FTIR. J. Mater. Sci. 2005, 40, 71–76. [Google Scholar] [CrossRef]
- Singh, P.K.; Singh, V.K.; Singh, M. Zwitterionic polyelectrolytes: A review. e-Polymers 2007, 7, 1–15. [Google Scholar] [CrossRef]
- Goda, T.; Ishihara, K.; Miyahara, Y. Critical update on 2-methacryloyloxyethyl phosphorylcholine (MPC) polymer science. J. Appl. Polym. Sci. 2015, 132, 41766. [Google Scholar] [CrossRef]
- ISO 10477; Dentistry—Polymer-Based Crown and Bridge Materials. International Organization for Standardization: Geneva, Switzerland, 2020.
- Zhang, N.; Melo, M.A.S.; Chen, C.; Liu, J.; Weir, M.D.; Bai, Y.; Xu, H.H.K. Development of a multifunctional adhesive system for prevention of root caries and secondary caries. Dent. Mater. 2015, 31, 1119–1131. [Google Scholar] [CrossRef] [PubMed]
- Alammar, A.; Att, W.; Beuer, F. The accuracy of 3D-printed fixed dental restorations. J. Esthet. Restor. Dent. 2024; in press. [Google Scholar]
- Zhang, S.; Wang, X.; Yang, J.; Chen, H.; Jiang, X. Micromechanical interlocking structure at the filler/resin interface for dental composites: A review. Int. J. Oral Sci. 2023, 15, 21. [Google Scholar] [CrossRef]
- Santoliquido, O.; Colombo, P.; Ortona, A. Additive Manufacturing of ceramic components by Digital Light Processing: A comparison between the “bottom-up” and the “top-down” approaches. J. Eur. Ceram. Soc. 2019, 39, 2140–2148. [Google Scholar] [CrossRef]
- Dufaud, O.; Marchal, P.; Corbel, S. Rheological properties of PZT suspensions for stereolithography. J. Eur. Ceram. Soc. 2002, 22, 2081–2092. [Google Scholar] [CrossRef]
- Kim, J.-H.; Maeng, W.-Y.; Koh, Y.-H.; Kim, H.-E. Digital light processing of zirconia prostheses with high strength and translucency for dental applications. Ceram. Int. 2020, 46, 28211–28218. [Google Scholar] [CrossRef]

| Role | Inorganic Filler | Photocurable Binders | ||
|---|---|---|---|---|
| Material | γ-MPS treated Silica-Zirconia | Urethane Dimethacrylate (UDMA) | Triethylene Glycol Dimethacrylate (TEGDMA) | 2-Hydroxyethyl Methacrylate (HEMA) |
| Supplier | Sukgyung AT (Gyeonggi-do, Republic of Korea) | Sigma Aldrich (St. Louis, MO, USA) | TCL chemical (Portland, OR, USA) | Sigma Aldrich (St. Louis, MO, USA) |
| Role | Zwitterionic material | Dispersant | Photo-initiator | |
| Material | 2-Methacryloyloxyethyl Phosphorylcholine (MPC) | BYK-2001 | Diphenyl(2,4,6-trimethylbenzoyl) Phosphine oxide (TPO) | |
| Supplier | KCI Limited (Seoul, Republic of Korea) | BYK-Chemie (GmbH, Wesel, Germany) | Sigma Aldrich (St. Louis, MO, USA) | |
| Role | Photocurable Binders | Zwitterionic Material | Photo-Initiator |
|---|---|---|---|
| Material | UDMA | MPC | TPO |
| TEGDMA | |||
| HEMA | |||
| Amount [g] | 20.0 | 0 | 0.1 |
| 19.8 | 0.2 | 0.099 | |
| 19.4 | 0.6 | 0.097 | |
| 19.0 | 1.0 | 0.095 | |
| 18.6 | 1.4 | 0.093 | |
| Weight fraction [wt%] | 99.5 | 0 | 0.5 |
| 98.5 | 1.0 | 0.5 | |
| 96.5 | 3.0 | 0.5 | |
| 94.5 | 5.0 | 0.5 | |
| 92.5 | 7.0 | 0.5 |
| Role | Photocurable Binders | Zwitterionic Material | Inorganic Filler | Dispersant | Photo Initiator |
|---|---|---|---|---|---|
| Material | UDMA | MPC | γ-MPS treated Silica-Zirconia | BYK-2001 | TPO |
| TEGDMA | |||||
| HEMA | |||||
| Amount [g] | 18.6 | 1.4 | 5.4 | 0.2 | 0.093 |
| 12.4 | 0.4 | ||||
| 21.5 | 0.6 | ||||
| 33.8 | 1.0 | ||||
| Weight fraction [wt%] | 72.4 | 5.4 | 21.0 | 0.8 | 0.4 |
| 56.5 | 4.3 | 37.7 | 1.2 | 0.3 | |
| 44.1 | 3.3 | 51.0 | 1.4 | 0.2 | |
| 33.9 | 2.6 | 61.6 | 1.8 | 0.2 |
Disclaimer/Publisher’s Note: The statements, opinions and data contained in all publications are solely those of the individual author(s) and contributor(s) and not of MDPI and/or the editor(s). MDPI and/or the editor(s) disclaim responsibility for any injury to people or property resulting from any ideas, methods, instructions or products referred to in the content. |
© 2025 by the authors. Licensee MDPI, Basel, Switzerland. This article is an open access article distributed under the terms and conditions of the Creative Commons Attribution (CC BY) license (https://creativecommons.org/licenses/by/4.0/).
Share and Cite
Lee, Y.-H.; Jung, J.-M.; Kim, G.-N.; Koh, Y.-H. Resin Composites with Anti-Biofouling Zwitterionic Polymer and Silica/Zirconia Filler for Digital Light Processing (DLP) of Dental Protheses. Materials 2025, 18, 3677. https://doi.org/10.3390/ma18153677
Lee Y-H, Jung J-M, Kim G-N, Koh Y-H. Resin Composites with Anti-Biofouling Zwitterionic Polymer and Silica/Zirconia Filler for Digital Light Processing (DLP) of Dental Protheses. Materials. 2025; 18(15):3677. https://doi.org/10.3390/ma18153677
Chicago/Turabian StyleLee, Yun-Hee, Jae-Min Jung, Gyu-Nam Kim, and Young-Hag Koh. 2025. "Resin Composites with Anti-Biofouling Zwitterionic Polymer and Silica/Zirconia Filler for Digital Light Processing (DLP) of Dental Protheses" Materials 18, no. 15: 3677. https://doi.org/10.3390/ma18153677
APA StyleLee, Y.-H., Jung, J.-M., Kim, G.-N., & Koh, Y.-H. (2025). Resin Composites with Anti-Biofouling Zwitterionic Polymer and Silica/Zirconia Filler for Digital Light Processing (DLP) of Dental Protheses. Materials, 18(15), 3677. https://doi.org/10.3390/ma18153677

